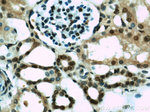
HIF1a Antibody in Immunohistochemistry (Paraffin) (IHC (P))

Search
Proteintech
HIF1a Polyclonal Antibody
{{$productOrderCtrl.translations['antibody.pdp.commerceCard.promotion.promotions']}}
{{$productOrderCtrl.translations['antibody.pdp.commerceCard.promotion.viewpromo']}}
{{$productOrderCtrl.translations['antibody.pdp.commerceCard.promotion.promocode']}}: {{promo.promoCode}} {{promo.promoTitle}} {{promo.promoDescription}}. {{$productOrderCtrl.translations['antibody.pdp.commerceCard.promotion.learnmore']}}
产品信息
20960-1-AP
种属反应
已发表种属
宿主/亚型
分类
类型
抗原
偶联物
形式
浓度
规格
纯化类型
保存液
内含物
保存条件
运输条件
产品详细信息
Immunogen sequence: LRSFDQLSP LESSSASPES ASPQSTVTVF QQTQIQEPTA NATTTTATTD ELKTVTKDRM EDIKILIASP SPTHIHKETT SATSSPYRDT QSRTASPNRA GKGVIEQTEK SHPRSPNVLS VALSQRTTVP EEELNPKILA LQNAQRKRKM EHDGSLFQAV GIGTLLQQPD DHAATTSLSW KRVKGCKSSE QNGMEQKTII LIPSDLACRL LGQSMDESGL PQLTSYD (574-799 aa encoded by BC012527 )
靶标信息
HIF1-alpha (HIF1A) is a subunit of HIF1, which is a transcription factor found in mammalian cells cultured under reduced oxygen tension. HIF-1 is a heterodimer consisting of an alpha and beta subunit, both belonging to the basic-helix-loop-helix Per-aryl hydrocarbon receptor nuclear translocator-Sim (PAS) family of transcription factors. HIF1 functions as a transcriptional regulator of the adaptive response to hypoxia. Under hypoxic conditions, HIF-1 activates the transcription of over 40 genes, including erythropoietin, glucose transporters, glycolytic enzymes, vascular endothelial growth factor, HILPDA, and other genes whose protein products increase oxygen delivery or facilitate metabolic adaptation to hypoxia. HIF1-alpha regulates hypoxia-mediated apoptosis, cell proliferation and tumor angiogenesis. Hypoxia which induces p53 protein accumulation, directly interacts with HIF1-alpha and reduces hypoxia-induced expression of HIF1-alpha by promoting MDM2-mediated ubiquitination and proteasomal degradation under hypoxic conditions. Recent studies suggest that induction of NOX4 by HIF1-alpha contributes to maintain ROS levels after hypoxia and hypoxia-induced proliferation. In humans, it is located on the q arm of chromosome 14. The C-terminal of HIF1A binds to p300. p300/CBP-HIF complexes participate in the induction of hypoxia-responsive genes, including VEGF. Hypoxia contributes significantly to the pathophysiology of major categories of human disease, including myocardial and cerebral ischemia, cancer, pulmonary hypertension, congenital heart disease and chronic obstructive pulmonary disease.
仅用于科研。不用于诊断过程。未经明确授权不得转售。
生物信息学
蛋白别名: ARNT interacting protein; ARNT-interacting protein; ARNT2; Basic-helix-loop-helix-PAS protein MOP1; bHLHe78; Class E basic helix-loop-helix protein 78; hif 1; hif 1a; HIF-1-alpha; HIF-1alpha 786; hypoxia inducible factor 1 alpha subunit; hypoxia inducible factor 1, alpha subunit (basic helix-loop-helix transcription factor); Hypoxia-inducible factor 1-alpha; hypoxia-inducible factor1alpha; Member of PAS protein 1; member of PAS superfamily 1; PAS domain-containing protein 8; transcription factor; transcription factor; hypoxia-inducible factor 1a; unnamed protein product
基因别名: BHLHE78; HIF-1-alpha; HIF-1A; HIF-1alpha; HIF1; HIF1-ALPHA; HIF1A; MOP1; PASD8
UniProt ID: (Human) Q16665
Entrez Gene ID: (Human) 3091